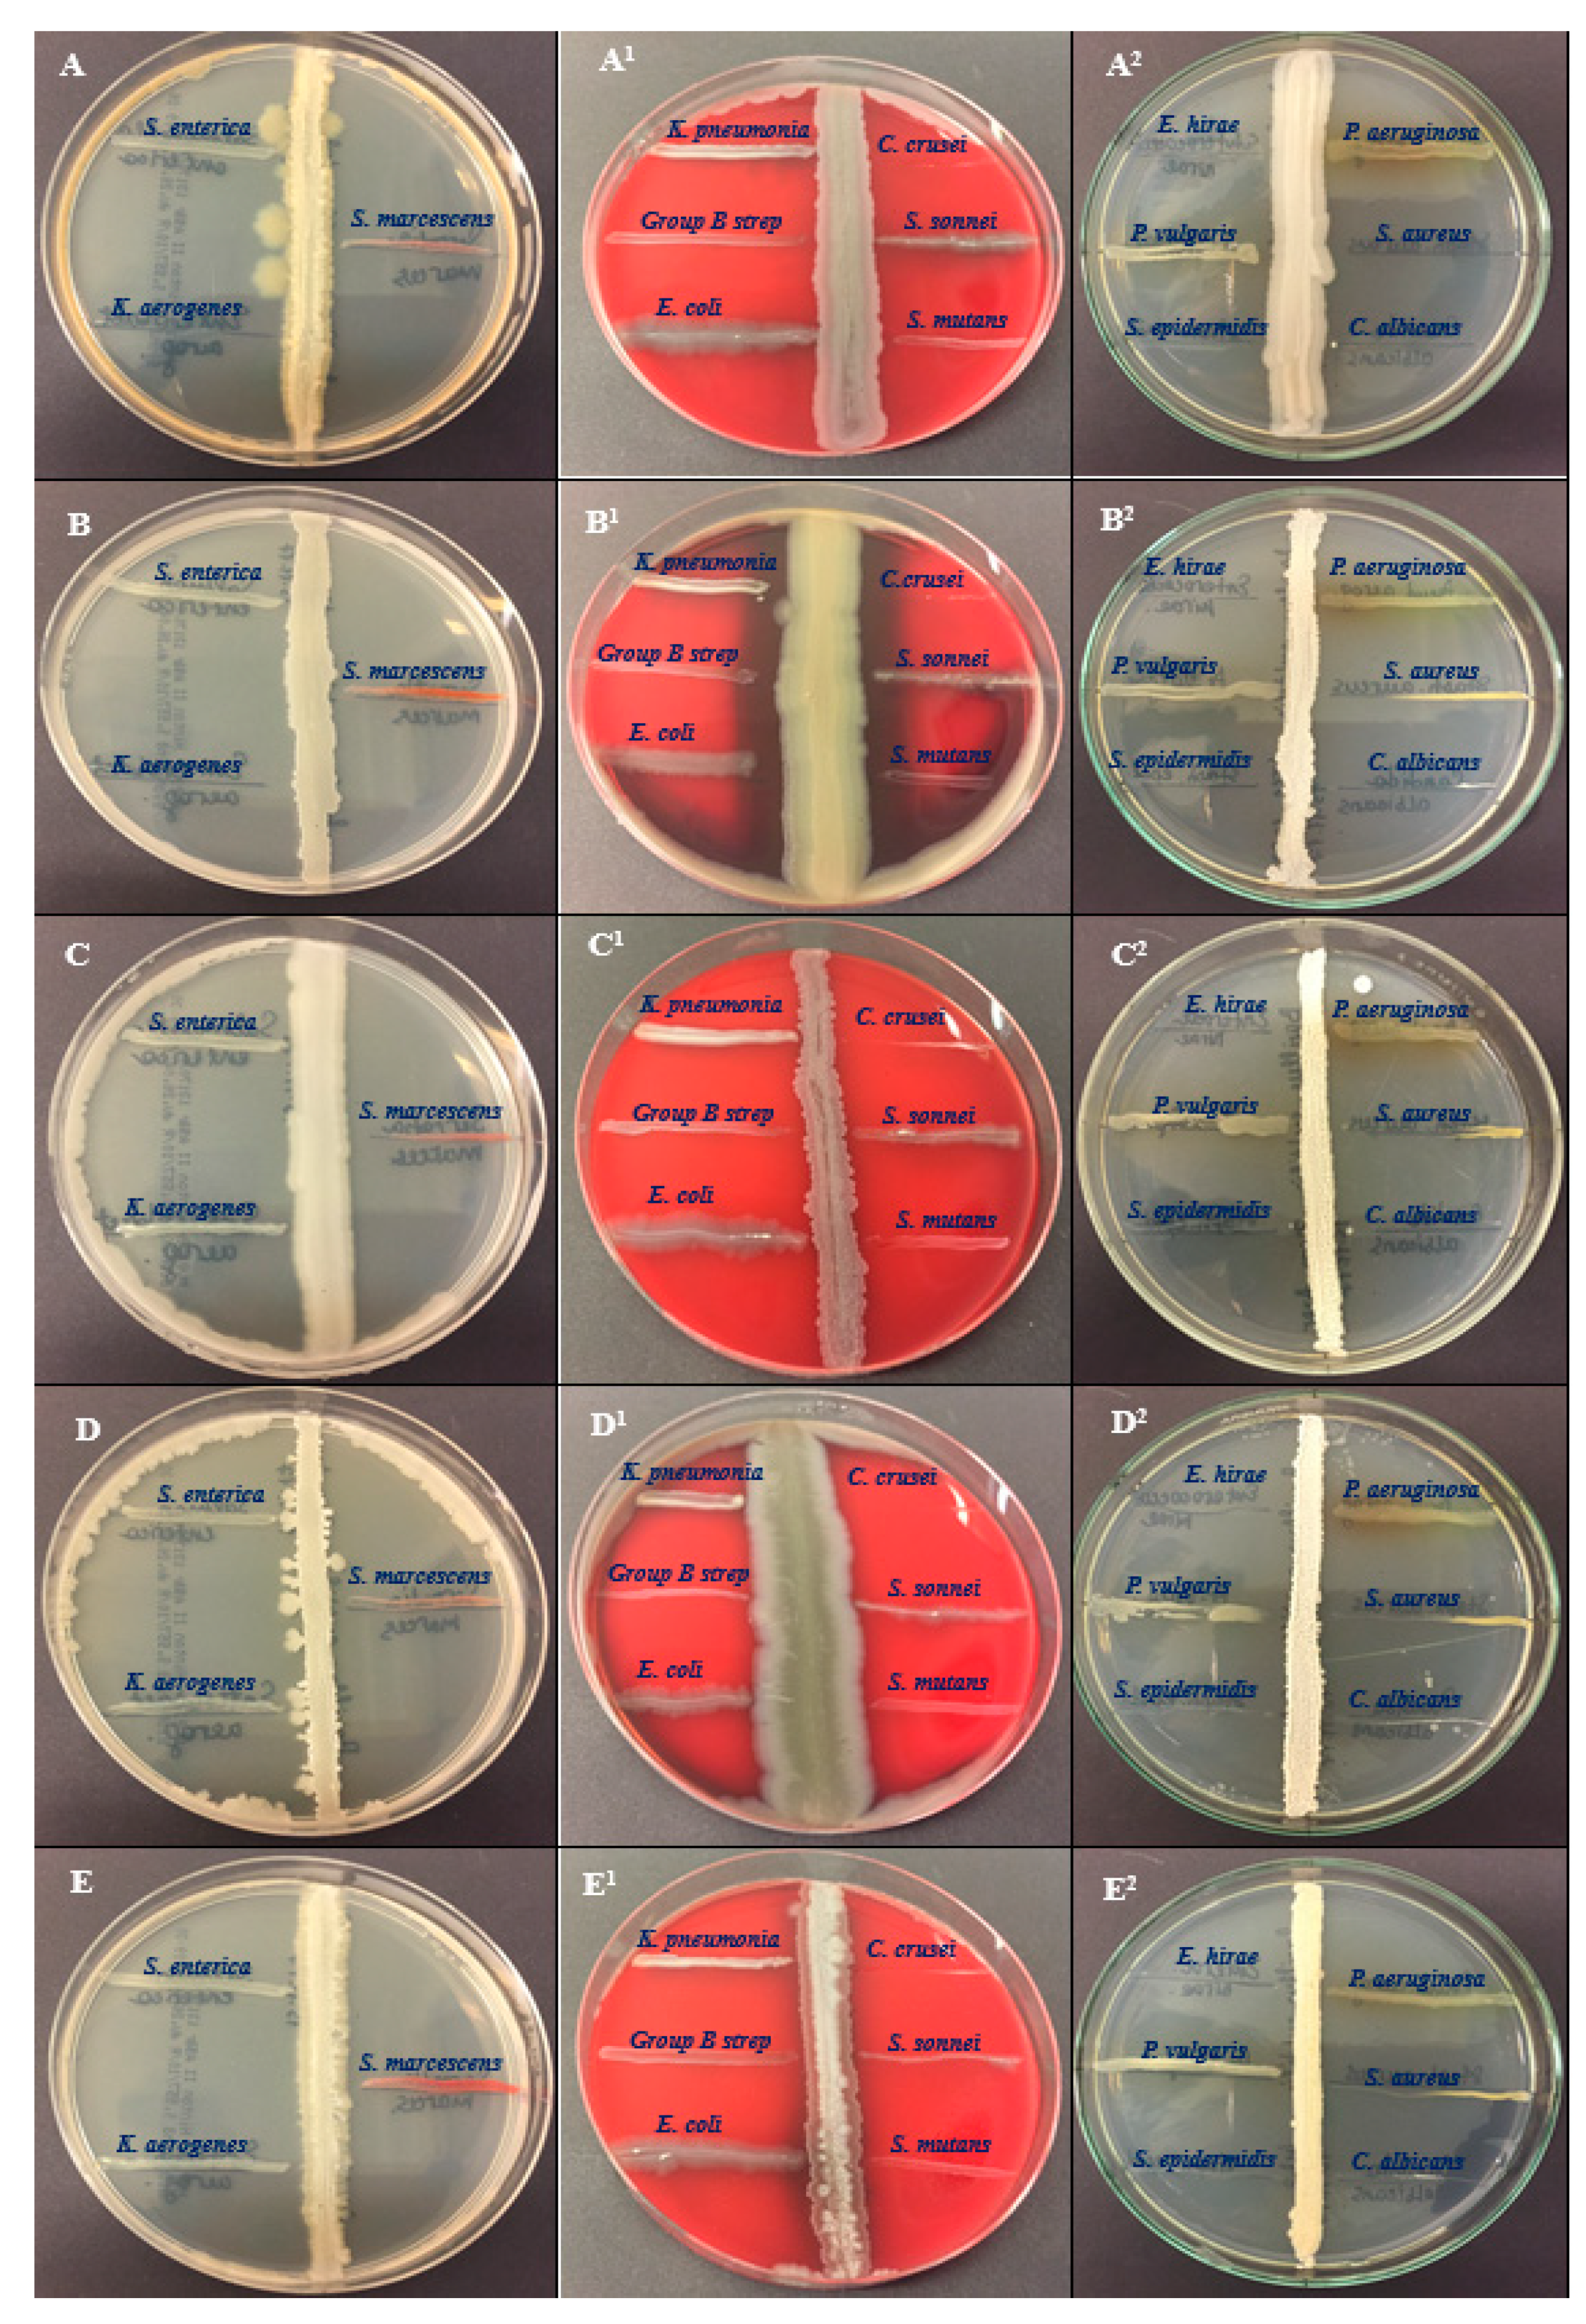

1. Introduction
The emergence of bacterial strains that previously were susceptible to existing antibiotics but now cause serious infectious diseases makes it necessary to find and create novel treatments for these illnesses [
1]. The most well-known and clinically significant example of this issue is the rise in multidrug-resistant strains of
Staphylococcus aureus (MRSA), which is most pathogenic and leads to the formation of an abscess. Moreover, it can cause pneumonia, endocarditis, and osteomyelitis. According to some investigations, MRSA is resistant not only to some antibiotics such as methicillin, macrolides, tetracycline, aminoglycosides, and chloramphenicol but also to some disinfectants [
2].
In order to create new antibiotic treatments or disinfectants, it is also necessary to look for and analyze compounds that have bactericidal or bacteriostatic capabilities against human and animal infections. Currently, analysis of the potential of natural compounds from various sources as antimicrobials has received significant attention in addition to the synthesis of new chemical substances. The observation of antagonism, or the interaction between microorganisms, is frequently the starting point for the development of antibiotics with activity against human infections. The creation and release of chemicals that impede or entirely stop the growth of other species serve as the physical manifestation of this hostility. Under natural circumstances, an agent released by a microbe that prevents the growth of another organism has an edge in the competition for environmental resources. The majority of antibiotics used in medicine are secreted by or derived from bacteria. Hence, it is a fact that the bacterial world has a vast repository of potentially antimicrobial chemicals that have not yet been identified or exploited. In this respect, members of the genus
Bacillus are recognized as manufacturers of a wide variety of enzymes and antibacterial substances. For example, 23 peptide antibiotics are produced by
Bacillus brevis, while
Bacillus subtilis produces roughly 70 antimicrobials which are ribosomal peptides, non-ribosomal peptides, polyketides, hybrids, and volatile compounds [
3,
4]. Consequently, there is increased interest in taking these compounds into consideration as disjunctive antimicrobials for the healing of human infections [
5,
6,
7,
8,
9].
Nowadays, a novel strategy for the management and prevention of numerous infectious illnesses is the use of bacterial probiotic strains and their metabolic products. Probiotics from the
Bacillus genus have been shown to exhibit antibacterial effects in experiments on animals. As an affordable and infrequently resistant alternative to antibiotics, the application of bacteriocins and antimicrobial peptides synthesized by probiotic strains is recommended [
13,
14]. They hold promise for clinical usage since many of these molecules are efficient and affordable [
15]. Due to their desirable medicinal qualities, such as their antibacterial, antiviral, anticancer, and contraceptive effects, a few natural peptides from bacterial isolates have demonstrated potential. Furthermore, when combined with traditional antibiotics, they have been demonstrated to offer protection against systemic and topical infections. Therefore, the justification for using probiotics in medicine is founded on the notion that giving oral or topically applied probiotics could restore the depleted state of the human microbiome [
16].
Development, registration, and commercialization of biocontrol drugs based on microbial antagonists have advanced significantly during the past few decades. Although their use has side effects on both human and animal health.
Bacillus species compete directly with fungal pathogens for resources and habitats and through a variety of processes such as the generation of siderophores. Hence, they also indirectly create systemic resistance or stimulate the growth of plants [
17,
18]. Moreover, they produce a vast array of volatile organic compounds with strong inhibitory potential against plant pathogens: alcohols, alkenes, benzenoids, terpenoids, ketones, sulfur-containing compounds, and others [
19,
20]. Non-volatile components of these metabolites have gotten a lot of scientific interest, whereas volatile components are examined less frequently. Numerous applications in biology, environmental sciences, health, the food industry, and national security include the study and detection of volatile organic compounds (VOCs) that come from or interact with creatures ranging from bacteria to people. Low-molecular-weight organic molecules with a lipophilic nature and a low boiling point are known as volatile organic compounds (VOCs) [
21]. According to several studies, VOCs released by bacteria may help plants by fostering development, triggering defence mechanisms, and inhibiting or removing dangerous infections [
22,
23,
24,
25,
26]. Furthermore, VOCs released by microorganisms are biodegradable as they are naturally occurring compounds. As a result, using VOCs produced by microorganisms is a sustainable method of crop protection and promotion. According to some recent studies, because they can stop certain pathogenic fungi's mycelial growth and spore germination, VOCs produced by
B. subtilis have been suggested as an alternate control approach for postharvest fruit illnesses [
27]. For instance, different VOCs produced by
B. subtilis TB09 and TB72, such as nonan-2-one, β-benzeneethanamine, and 2-methyl-1,4-diazine effectively controlled the anthracnose pathogen on postharvest mangoes [
28]. Likewise, some VOCs synthesized by
B. subtilis PPCB001 helped to evaluate its antagonistic activity and it was found that
B. subtilis PPCB001 reduces growth one of the imperfect fungi which is called
Penicillium crustosum [
29]. Additionally, the GC–MS analysis of three bacterial isolates of
Bacillus subtilis Md1-42,
Bacillus subtilis O-3, and
Bacillus subtilis Khozestan2 samples proved the presence of phenol, benzoic acid, 1,2-benzenedicarboxylic acid, bis(2-methylpropyl), methoxyphenyl-oxime, and benzaldehyde, which are known for their antimicrobial and other properties [
30].
Overall, representatives of the genus
Bacillus are found as producers of a wide range of antimicrobial compounds. The synergetic mechanism of antimicrobial compounds such as VOCs, polyketides, ribosomal peptides, and others explains why they have an increased industrial interest as therapeutic agents, food preservatives and biopesticides. Since
Bacillus species have the unique ability to produce a variety of diverse antibacterial chemicals, they can serve as a natural carrier for antibiotics in the form of probiotic cultures and strains to fight different pathogens, including mycobacteria. Nevertheless, the dangerous effects of several antibacterials on humans and animals have prevented some of them from being used medically despite their promising in vitro antimycobacterial activity [
31,
32].
Another instance of a
Bacillus species' employment is in the manufacture of food-grade amylase, glucoamylase, protease, pectinase, and cellulase in a variety of foods [
33,
34,
35,
36]. Additionally, many species of
Bacillus have been employed to synthesize a number of dietary supplements for human use, including vitamins (such as riboflavin, cobalamin, and inositol) and carotenoids [
36,
37,
38,
39]. However, despite the foregoing advantages, these strains have not attracted much interest in the contemporary functional food market because of their relationships with a limited number of human diseases.
This study focused on isolating potential Bacillus species from vegetable samples (potato, carrot, and tomato) and preparing a crude extract from isolated bacterial strains to assess antimicrobial activities against the most common human pathogens. In addition, bacterial isolates were tested for antibiotic resistance using an inhibition zone diameter when determined via the disk diffusion method. GC–MC analysis was performed to determine bioactive compounds from the bacterial isolates. This study will facilitate the development of novel antibiotics against MDR bacterial strains and help to explore possible probiotics typical for the representatives of the genus Bacillus.
3. Discussion
Microorganisms, including bacteria, archaea, fungi, and even viruses, inhabit diverse environments and contribute to the cycling of nutrients and the production of a wide array of metabolites. Especially extreme microbial diversity, abundance, and structure can have significant implications for the production of various metabolites with diverse functions, including anti-parasitic, antimicrobial, anti-pesticidal anti-cancerous functions. Consequently, these metabolites can have important applications in various fields. The goal of the present study was to investigate the possibility of particular vegetable microbial communities displaying antibacterial properties and to establish the possible relationship between isolated compounds through GC–MS and the antagonistic activity of studied bacterial strains. As a result of various phases of isolation, the identification of diverse general objectives with the selection of bacterial growth conditions, and biochemical tests, nineteen (n=19) different bacterial isolates were detected. In recent years, the ongoing exploration of microbial diversity, along with advancements in culturing techniques, genomics, and metagenomics, has rejuvenated the search for new antibiotics. This is a promising development in the fight against infectious diseases and antibiotic resistance, as it offers the potential for a new generation of antimicrobial agents to tackle previously untreatable infections [
75,
76]. However, both, mobile genetic elements and inherent characteristics (natural phenotypic traits) causes contribute to the development and spread of antibiotic resistance, making it a complex and evolving problem in healthcare and public health. The inappropriate use of antibiotics, both in clinical settings and in agriculture, accelerates the selection and dissemination of antibiotic-resistant bacteria by providing a selective advantage to those carrying resistance genes. Addressing antibiotic resistance requires a multifaceted approach that includes responsible antibiotic use, surveillance, development of new antibiotics, and strategies to prevent the spread of resistant bacteria [
77]. Nearly all antibiotics, with the exception of bacitracin, polymyxin, and cloxacillin, were found to be effective against
Bacillus species, i.e.,
Bacillus thuringiensis F3 (BSS25),
Bacillus toyonensis FORT 102 (BSS21),
Bacillus acidiproducens NiuFun (BSS16),
Bacillus cereus WAB2133 (BSS13), and
Bacillus safensis AS-08 (BSS12) (
Table 3). Similar findings on the susceptibility of various antibiotic-susceptible
Bacillus species were observed in some recent studies [
30,
78,
79,
80,
81]. Here, resistance in specific
Bacillus strains to particular antibiotics can result from both inherent (natural) mechanisms and acquired resistance due to the presence of resistance genes associated with the production of resistance enzymes [
82]. The probability of passing on resistance genes to other bacteria, particularly dangerous pathogens, may be lower when resistance is due to inherent (natural) resistance mechanisms rather than acquired resistance through the acquisition of resistance genes. This distinction is important in the context of antibiotic resistance transmission and the potential for the development of multidrug-resistant or extensively drug-resistant bacteria. Since antibiotic resistance has indeed become a serious global concern, and the spread of resistant bacteria through the food chain is one of the pathways contributing to this problem [
83]. Although, Isolated
Bacillus strains may not necessarily harbor antibiotic resistance genes that can be horizontally transferred to dangerous pathogens, but they can still exhibit natural resistance or insensitivity to a wide variety of antibiotics due to their inherent characteristics. Indeed, further research into
Bacillus strains, especially those with unique characteristics or inherent resistance to antibiotics, can be valuable for various applications, including the development of probiotic starter cultures and the production of high-quality, medicinal, and health-promoting substances.
Gas Chromatography–Mass Spectrometry (GC–MS) is a powerful analytical technique commonly used to detect and identify various compounds in biological samples, including microbial cells and their metabolites helped in this study to detect markers in biological material, such as components of microbial cells and metabolites like fatty acids, aldehydes, and phenolic compounds. Additionally, using GC–MS without the need for the preliminary isolation of pure cultures of microorganisms offers several advantages in the case of both endogenous and exogenous microflora, which is especially important when considering the difficulties in cultivating anaerobes. The method's unique benefits were quick analytical times and the capacity to quantify marker content. According to the GC–MS analysis, the
Bacillus species produce a variety of chemicals (
Table 9), which possess different pharmacological activities such as antiviral, antibacterial, antifungal, antioxidant, anticancer, anti-inflammatory, hyperlipidemic, antimicrobial, antinociceptive, analgesic, anxiolytic, anti-depressive, neuroprotective and so on. Overall, 69 compounds were determined by the GC–MS analysis of their crude metabolites from five
Bacillus species. 8 biologically active compounds such as acetoin, acetic acid, butanoic acid, 2-methyl-, oxime-, methoxy-phenyl, phenol, 1,2-benzenedicarboxylic acid, bis(2-methylpropyl) ester, nonanoic acid, and hexadecanoic acid, methyl ester were found as common for all five strains (
Table 4,
Table 5,
Table 6,
Table 7, and
Table 8 and
Figure 2).
Previously, we found that acetic acid is present in bacterial isolates such as
Bacillus subtilis O-3,
Bacillus subtilis Md1-42, and
Bacillus subtilis Khozestan2 [
30]. According to the present study acetic acid seems a common organic compound almost for all
Bacillus species as its presence is confirmed in other five
Bacillus species i.e.
Bacillus toyonensis FORT 102,
Bacillus acidiproducens NiuFun,
Bacillus cereus WAB2133, and
Bacillus safensis AS-08. BSS13 has the highest concentration of acetic acid at 6.313543%, while the other four strains were found to share similar low concentrations. Acetic acid is a common organic acid and a component of the volatile organic compounds (VOCs) produced by some bacterial species, including certain strains of Bacillus. Acetic acid is a byproduct of microbial metabolism, particularly in bacteria that undergo fermentation processes or produce acetic acid as part of their metabolic pathways. It has been known for antibacterial and antifungal, anticancer activities [
50]. The second common compound for all five strains was acetoin, and its concentration for BSS25, BSS21, BSS16, BSS13, and BSS12 were different as follows 44.063%, 38.25336%, 8.440992%, 0.745862%, and 0.263788%, respectively. Acetoin is a common compound produced by various bacteria, and its concentration can vary among different strains. It is not typically used as a central nervous system (CNS) depressant in medical practice or for recreational purposes. However, in one recent study, it was proven that acetoin has a potent CNS depressant effect [
44]. It was found that the third component that all bacteria share is butanoic acid, 2-methyl-, which has an application as a laxative. BSS16 and BSS13 have the highest concentrations of butanoic acid, 2-methyl- at 29.3946% and 31.6913%, while BSS16, BSS13, and BSS12 share very low concentrations at 2.237883%, 3.572379, and 1.894643, respectively. Other 4 compounds common for all five strains, which are oxime-, meth-oxy-phenyl, 1,2-benzenedicarboxylic acid, bis(2-methylpropyl) ester, nonanoic acid, and hexadecanoic acid, methyl ester, were found at low concentrations similarly to each other.
The GC-MS analysis of Bacillus thuringiensis F3 has revealed the presence of several chemical compounds of 2,3-butanedione, 2,3-butanediol, [S-(R*,R*)]-, 1-hepten-4-ol, hexanoic acid, hexanoic acid, 2-ethyl-, octanoic acid, benzaldehyde, (S)-(+)-6-methyl-1-octanol in relatively high concentrations at 15.84782%, 4.077882%, 3.418443%, 1.862169%, 2.90418%, 2.465807%, 2.222227%, and 1.248967%, respectively. The compositional study of Bacillus toyonensis FORT 102 established that it differs from other bacterial strains by composing of 2,3-butanedione (16,97044%), propanoic acid, 2-methyl- (1.406486%), hexadecanoic acid (4.002248%), oleic acid (5.853397%), 9,12-octadecadienoic acid (Z,Z)- (3.796889%), 2,3-pentanedione (2,035411%), 3-pentanol, 2-methyl- (2.916132%), oxirane, (methoxymethyl)- (2.409396%), 2,3-butanediol, [S-(R*,R*)]- (7.796162%), hexadecanoic acid (4.002248%), 9,12-octadecadienoic acid (Z,Z)- (3.796889%). The presence of some valuable compounds in Bacillus acidiproducens NiuFun also was confirmed, which are benzaldehyde (4.751143%); 3(2H)-thiophenone, dihydro-2-methyl- (6.072668%), propanoic acid, 2-methyl- (13.97511%), hexadecanoic acid (3.60544%), octadecanoic acid (1.638403%), oleic acid (9.677555%), and 9,12-octadecadienoic acid (Z,Z)- (11.09688%). The presence of some valuable compounds in Bacillus acidiproducens NiuFun also was confirmed, which are benzaldehyde (4.751143%); 3(2H)-thiophenone, dihydro-2-methyl- (6.072668%), propanoic acid, 2-methyl- (13.97511%), hexadecanoic acid (3.60544%), octadecanoic acid (1.638403%), oleic acid (9.677555%), and 9,12-octadecadienoic acid (Z,Z)- (11.09688%) and the presence of these chemical constituents indicates a diverse metabolic capacity of this bacterium. Finally, the specific VOCs with high concentrations produced by Bacillus safensis AS-08 were as 2,3-butanedione (21.42702%), 3-pentanol, 2-methyl- (36.53327%), benzaldehyde (2.170694%), 2,3-butanediol (4.672893%), propanoic acid, 2-methyl- (3.156132%), oleic acid (4.585822%), and 9,12-octadecadienoic acid (Z,Z)- (3.576243).
Additionally, the GC–MS analysis showed that all five bacterial isolates contained various fatty acids along with other volatile organic compounds. It is well-known that fatty acids and their derivatives can exhibit powerful antibacterial and antifungal activities [
52,
53,
54,
55,
56,
57,
58,
59,
60,
61,
62,
63,
64,
65,
66,
67,
68]. Indeed, fatty acids are known for their biodegradability, low toxicity, and resistance to extremes in pH, salinity, and temperature, which make them environmentally friendly compounds. These properties have led to their acceptance and use as food additives in various applications. Antifungal fatty acids, particularly those found in natural sources, may have a lower likelihood of inducing resistance in pathogenic fungi compared to some synthetic antifungal drugs [
84]. The identification of volatile compounds, including esters, alkaloids, ethers, and phenolics, in five different
Bacillus species, is noteworthy and suggests a diverse array of secondary metabolites produced by these bacteria. The presence of volatile organic compounds (VOCs) as major constituents of a bacterial strain with properties against phytopathogens is significant and highlights the potential of these bacteria for various agricultural and environmental applications. The presence of common volatile compounds among different
Bacillus species suggests the existence of conserved metabolic pathways or biochemical processes within the genus
Bacillus. These shared compounds may be indicative of fundamental metabolic activities that are essential for the survival and growth of these bacteria. Our findings support prior research on the chemical composition of bacterial strains using GC–MS and show that
Bacillus spp. share similar volatile chemicals [
30,
85,
86,
87,
88].
The antibacterial characteristic of certain microorganisms, including
Bacillus strains, plays a crucial role in various therapeutic activities. The perpendicular streak method is a common laboratory technique used to assess the antibacterial properties of bacterial isolates against selected human bacterial pathogens. In the present study, this method was used to analyze the antibacterial potency of the bacterial isolates labeled as BSS25, BSS21, BSS16, BSS13 and BSS12 against the selected human bacterial pathogens. It can be explained with the help of bioactive compounds produced by bacteria, which can have various effects on other organisms, including antimicrobial. The perpendicular streak method is recognized as a first-pass qualitative screening method for the detection of microbial activity, particularly when assessing the antibacterial properties of bacterial isolates. The research demonstrated strong antagonistic action against human pathogens such as
Enterococcus hirae and
Staphylococcus epidermidis by all bacterial isolates. It is obvious that the synergistic contribution of antibacterial potency refers to the combined effect of two or more antimicrobial agents (such as antibiotics or other antimicrobial com-pounds) that work together to produce a stronger inhibitory or bactericidal effect against bacteria than the individual agents would achieve on their own. According GC–MS analysis, many compounds out 69 were identified with antibacterial potency (
Table 9) and their synergetic contribution explains how all bacterial strains have shown strong antagonistic action against
Enterococcus hirae and
Staphylococcus epidermidis. Moreover, the current research provided indicates that bacterial isolates BSS25, BSS21, and BSS16 exhibit strong antagonistic activity against
Candida albicans while BSS25, BSS21, and BSS13 suppress the growth or activity of
Candida krusei. Additionally, only BSS25 and BSS21 were found to show being studied exhibited strong inhibitory effects against
Klebsiella aerogenes. This may be due to the high concentrations of acetoin in BSS25 and BSS21 and butanoic acid, 2-methyl- in BSS16 and BSS13. For sure acetoin and butanoic acid, 2-methyl- enhances the antibacterial potency of bacterial strains along with other organic volatile compounds, peptides, etc.
These are positive results, suggesting that these bacterial isolates may have potential applications in controlling or preventing infections caused by these human pathogens. Our results showed that
Bacillus thuringiensis F3,
Bacillus toyonensis FORT 102,
Bacillus acidiproducens NiuFun,
Bacillus cereus WAB2133, and
Bacillus safensis AS-08 are effective at inhibiting the growth of some multidrug-resistant bacterial strains and this is similar to findings of our previous study [
30]. Previuos researches found that the inhibitory impact of
Bacillus species on other microorganisms, including pathogens, can indeed be attributed to various factors, including the pH of the growing medium and the generation of volatile chemicals.
Bacillus species are known to produce a variety of polypeptide antibiotic substances, including bacitracin, polymyxin, gramicidin S, and tyrothricin. These antibiotic substances have shown effectiveness against a wide range of bacteria, including both Gram-positive and Gram-negative bacteria [
88].
Bacterial extract investigation is a versatile and interdisciplinary field with far-reaching implications for science, medicine, agriculture, and industry. It involves the discovery and characterization of compounds and biological activities that can address various challenges and opportunities in these domains. Bacterial extracts are screened to discover novel antibiotic compounds, and antimicrobial peptides (AMPs) with potential therapeutic applications, as bacteria produce a wide variety of substances. Moreover, bacterial extracts can be a source of potential drug candidates for the treatment of various diseases, including infectious diseases and cancer. According to recent studies, bacterial extracts are also used in bioassays to evaluate the biological activity of compounds, including screening for enzyme inhibitors or activators while more of the studies proved the value of bacterial extracts' use in agriculture to manage plant diseases and pests. For example,
Bacillus species are known for their significant roles in agriculture and biotechnology, primarily due to their ability to produce various bioactive compounds that can benefit plant health and promote agricultural sustainability [
89,
90]. Moreover, bacterial extracts are analyzed to identify probiotic strains with potential benefits for gut health.
Molecular investigations can provide valuable insights into the taxonomy and genetic relatedness of different bacterial isolates and our results revealed the taxonomy of five different isolated species of Bacillus, which are Bacillus thuringiensis F3, Bacillus toyonensis FORT 102, Bacillus acidiproducens NiuFun, Bacillus cereus WAB2133, and Bacillus safensis AS-08. It was determined that the five most viable candidates of bacterial isolates BSS25, BSS21, BSS16, BSS13 and BSS12 belong to Bacillus thuringiensis F3 (99%), Bacillus toyonensis FORT 102 (99%), Bacillus acidiproducens NiuFun (99%), Bacillus cereus WAB2133 (99%), and Bacillus safensis AS-08 (99%), respectively, based on top hit sequence similarity results and phylogenetic analysis.
The identification of the five separate bacterial strains (Bacillus thuringiensis F3, Bacillus toyonensis FORT 102, Bacillus acidiproducens NiuFun, Bacillus cereus WAB2133, and Bacillus safensis AS-08) and their antibacterial activity can significantly facilitate microbial screening and the isolation of active metabolites, especially against multidrug-resistant strains. Consequently, knowing the specific strains that exhibit antibacterial activity allows for targeted screening of these strains against multidrug-resistant bacterial strains. This targeted approach saves time and resources compared to screening a wide range of microorganisms. As the antibacterial activity is confirmed, the isolation and purification of bioactive metabolites from these strains can be prioritized. This is crucial for identifying the specific compounds responsible for the antibacterial effects. Moreover, the isolated bioactive compounds may have potential as antibiotic adjuvants, especially against multidrug-resistant strains. This can be a valuable contribution to the fight against antibiotic resistance. Additionally, these compounds may serve as lead compounds for drug discovery efforts, where further modifications or structural optimization can be performed to enhance their efficacy and reduce potential side effects. Overall, the identification of metabolites from bacterial strains and evaluation of their antibacterial and antibiotic activity provides a strong foundation for focused research and applications in various fields.